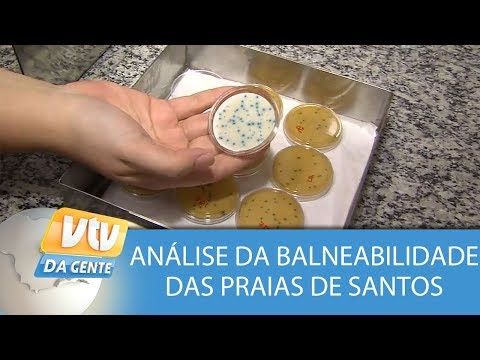

Balneabilidade Das Praias }}- Confira uma reportagem em um laboratório da Prefeitura de Santos que verifica a balneabilidade das praias. Clique no link para se INSCREVER!
Before downloading Balneabilidade Das Praias Videos , The world largest online music service. Listen online, find out more about your favourite artists, and get music recommendations.
Balneabilidade Das Praias Free Download Youtube Audio Mp3 and Mp4 :
Music Discovery, Charts and Song Lyrics : Veja Como é Feita A Análise Da Balneabilidade Das Praias | Balneabilidade Das Praias
Veja como é feita a análise da balneabilidade das praias - Balneabilidade Das Praias - Confira uma reportagem em um laboratório da Prefeitura de Santos que verifica a balneabilidade das praias. Clique no link para se INSCREVER!
Music Discovery, Charts and Song Lyrics : Balneabilidade Das Praias | Balneabilidade Das Praias
Music Discovery, Charts and Song Lyrics : Balneabilidade Das Praias De Santa Catarina | Balneabilidade Das Praias
Balneabilidade das praias de Santa Catarina - Balneabilidade Das Praias - Siga o SBT SC também nas Redes Sociais: http://facebook.com/SBTSConline http://instagram.com/sbtsc/ http://twitter.com/sbtsc http://sbtsc.com.br/
Music Discovery, Charts and Song Lyrics : Aplicativo ‘Praia Segura’ Informa Balneabilidade Das Praias De SC | Balneabilidade Das Praias
Aplicativo ‘Praia Segura’ informa balneabilidade das praias de SC - Balneabilidade Das Praias - O aplicativo 'Praia Segura' do Corpo de Bombeiros Militar de Santa Catarina possui uma nova funcionalidade, a balneabilidade das praias catarinenses, ...
Music Discovery, Charts and Song Lyrics : Período De Estiagem Favorece Balneabilidade Das Praias Em Florianópolis | Balneabilidade Das Praias
Período de estiagem favorece balneabilidade das praias em Florianópolis - Balneabilidade Das Praias - Falta pouco para a temporada de verão começar, e com ela vem a preocupação com a balneabilidade das praias e dos rios. A equipe da RICTV | Record ...
Identify the media playing around you Balneabilidade Das Praias explore the music you love [ Discover song lyrics from your favourite artists Período de estiagem favorece balneabilidade das praias em Florianópolis, Balneabilidade Das Praias &] Music Mp3 and Mp4 download that gives you an access to thousand of songs. Download free music, free Mp3, Free Mp4, top charts, playlists, new releases and offline listening.
Post a Comment
Post a Comment